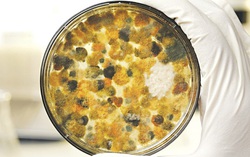

TAG thực phẩm mốc
Nhận diện thực phẩm chứa aflatoxin gây ung thư
Phòng & chữa bệnh 13:20 24/02/2020Aflatoxin ngoài việc dẫn đến ung thư gan, nó còn gây ung thư dạ dày, ung thư thận, ung thư trực tràng, ung thư vú, buồng trứng, ruột non, cũng có thể gây dị dạng, đột biến, quái thai.
